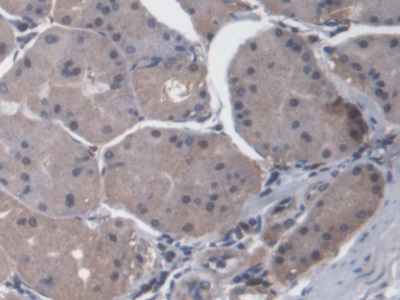
https://d1vffmuvmgkypt.cloudfront.net/image/ridacom_ltd/cloud_clone_corp/PRODUCT_SOURCE__CLOUD_CLONE__SUPPLIER__RIDACOM__ID__PAB607Hu01__2

Antigen
CXCL14
Reactivity
Human
(6)
Mouse
(5)
Rat
(2)
Research area
Cytokine
(4)
Infection immunity
(4)
Application
Western Blotting
(6)
Chemiluminescent immunoassay for antigen detection
(3)
Enzyme-linked immunosorbent assay for Antigen Detection
(3)
Immunohistochemistry
(3)
Immunocytochemistry
(2)
Immunoprecipitation
(2)
Positive Control
(2)
SDS-PAGE
(2)
ELISA
(1)
Supplier
Cloud-Clone Corp.
(10)
Abbkine Scientific Co., Ltd.
(1)
Affinity Biosciences
(1)
Category
ELISA Kits
(6)
Antibodies
(4)
Cell biology
(2)
Immunochemicals
(2)
Protein Biochemistry
(2)
| 48T | $638.00 | |
| 96T | $912.00 | |
| 96T*5 | $4,104.00 |
| 96T*10 | $7,752.00 | |
| 96T*100 | $63,840.00 |
| 48T | $605.00 | |
| 96T | $864.00 | |
| 96T*5 | $3,888.00 |
| 96T*10 | $7,344.00 | |
| 96T*100 | $60,480.00 |
| 48T | $588.00 | |
| 96T | $840.00 | |
| 96T*5 | $3,780.00 |
| 96T*10 | $7,140.00 | |
| 96T*100 | $58,800.00 |
| 48T | $505.00 | |
| 96T | $722.00 | |
| 96T*5 | $3,249.00 |
| 96T*10 | $6,137.00 | |
| 96T*100 | $50,540.00 |
| 48T | $479.00 | |
| 96T | $684.00 | |
| 96T*5 | $3,078.00 |
| 96T*10 | $5,814.00 | |
| 96T*100 | $47,880.00 |
| 48T | $466.00 | |
| 96T | $665.00 | |
| 96T*5 | $2,993.00 |
| 96T*10 | $5,653.00 | |
| 96T*100 | $46,550.00 |

Antigen:
Breast And Kidney Expressed Chemokine
Synonyms: CXCL14; SCYB14; BRAK; NJAC; Bolekine; Kec; MIP2-G; MIP2g; BMAC; KS1; Chemokine(C-X-C-Motif)ligand 14; Small Inducible Cytokine Subfamily B(Cys-X-Cys)Member 14
Reactivity:Mouse
Application:Positive Control; SDS-PAGE; Western Blotting
Research area:Cytokine; Infection immunity
Preparation method:Escherichia coli
| 10µg | $180.00 | |
| 50µg | $450.00 | |
| 200µg | $900.00 |
| 1mg | $2,700.00 | |
| 5mg | $6,750.00 |

Antigen:
Breast And Kidney Expressed Chemokine
Synonyms: CXCL14; SCYB14; BRAK; NJAC; Bolekine; Kec; MIP2-G; MIP2g; BMAC; KS1; Chemokine(C-X-C-Motif)ligand 14; Small Inducible Cytokine Subfamily B(Cys-X-Cys)Member 14
Reactivity:Human
Application:Positive Control; SDS-PAGE; Western Blotting
Research area:Cytokine; Infection immunity
Preparation method:Escherichia coli
| 10µg | $170.00 | |
| 50µg | $426.00 | |
| 200µg | $852.00 |
| 1mg | $2,556.00 | |
| 5mg | $6,390.00 |
CXCL14 Antibody
$280.00

Antigen:
C-X-C motif chemokine 14
Synonyms: Chemokine BRAK; MIP-2G; Small-inducible cytokine B14; CXL14_HUMAN; B3KQU8; O95715; Q6UW97; Q86U69; Q9BTR1; Q9NS21
Host:Rabbit
Reactivity:Human
Application:Western Blotting; Immunohistochemistry
Isotype:IgG
Clonality:Polyclonal
Aliases:1110031L23Rik; 1200006I23Rik; AI414372; BMAC; bolekine; BRAK; Breast and kidney; C-X-C motif chemokine 14; C-X-C motif chemokine ligand 14; Chaemokine, CXC motif, ligand 14; Chemokine (C-X-C motif) ligand 14; Chemokine BRAK; CXC chemokine in breast and kidney; CXCL14; CXL14_HUMAN; JSC; Kec; Kidney-expressed chemokine CXC; KS1; MGC10687; MGC124510; MGC90667; MIP 2 gamma; MIP-2G; MIP2G; MIP2gamma; NJAC; PRO273; PSEC0212; Scyb14; Small Inducible Cytokine B14; Small inducible cytokine subfamily B (Cys-X-Cys) member 14 (BRAK); Small Inducible Cytokine subfamily B, member 14; Small-inducible cytokine B14; Tumor suppressing chemokine; UNQ240
| 100μl | $280.00 |
| 200μl | $350.00 |

Antigen:
Breast And Kidney Expressed Chemokine
Synonyms: CXCL14; SCYB14; BRAK; NJAC; Bolekine; Kec; MIP2-G; MIP2g; BMAC; KS1; Chemokine(C-X-C-Motif)ligand 14; Small Inducible Cytokine Subfamily B(Cys-X-Cys)Member 14
Host:Rabbit
Reactivity:Mouse
Application:Western Blotting; Immunohistochemistry; Immunocytochemistry; Immunoprecipitation
Clonality:Polyclonal
Research area:Cytokine; Infection immunity
| 20µl | $103.00 | |
| 100µl | $239.00 | |
| 200µl | $342.00 |
| 1ml | $855.00 | |
| 10ml | $3,420.00 |

Antigen:
Breast And Kidney Expressed Chemokine
Synonyms: CXCL14; SCYB14; BRAK; NJAC; Bolekine; Kec; MIP2-G; MIP2g; BMAC; KS1; Chemokine(C-X-C-Motif)ligand 14; Small Inducible Cytokine Subfamily B(Cys-X-Cys)Member 14
Host:Rabbit
Reactivity:Human
Application:Western Blotting; Immunohistochemistry; Immunocytochemistry; Immunoprecipitation
Clonality:Polyclonal
Research area:Cytokine; Infection immunity
| 20µl | $100.00 | |
| 100µl | $232.00 | |
| 200µl | $332.00 |
| 1ml | $830.00 | |
| 10ml | $3,320.00 |
CXL14 Polyclonal Antibody
$100.00

Antigen:
C-X-C motif chemokine 14
Synonyms: Chemokine BRAK; MIP-2G; Small-inducible cytokine B14; CXL14_HUMAN; B3KQU8; O95715; Q6UW97; Q86U69; Q9BTR1; Q9NS21
Host:Rabbit
Reactivity:Human; Mouse
Application:Western Blotting; ELISA
Isotype:IgG
Clonality:Polyclonal







-SCB607Mu-000001.png)






-SEB607Ra-000001.png)



-SEB607Mu-000001.png)



-E91607Hu-000001.png)